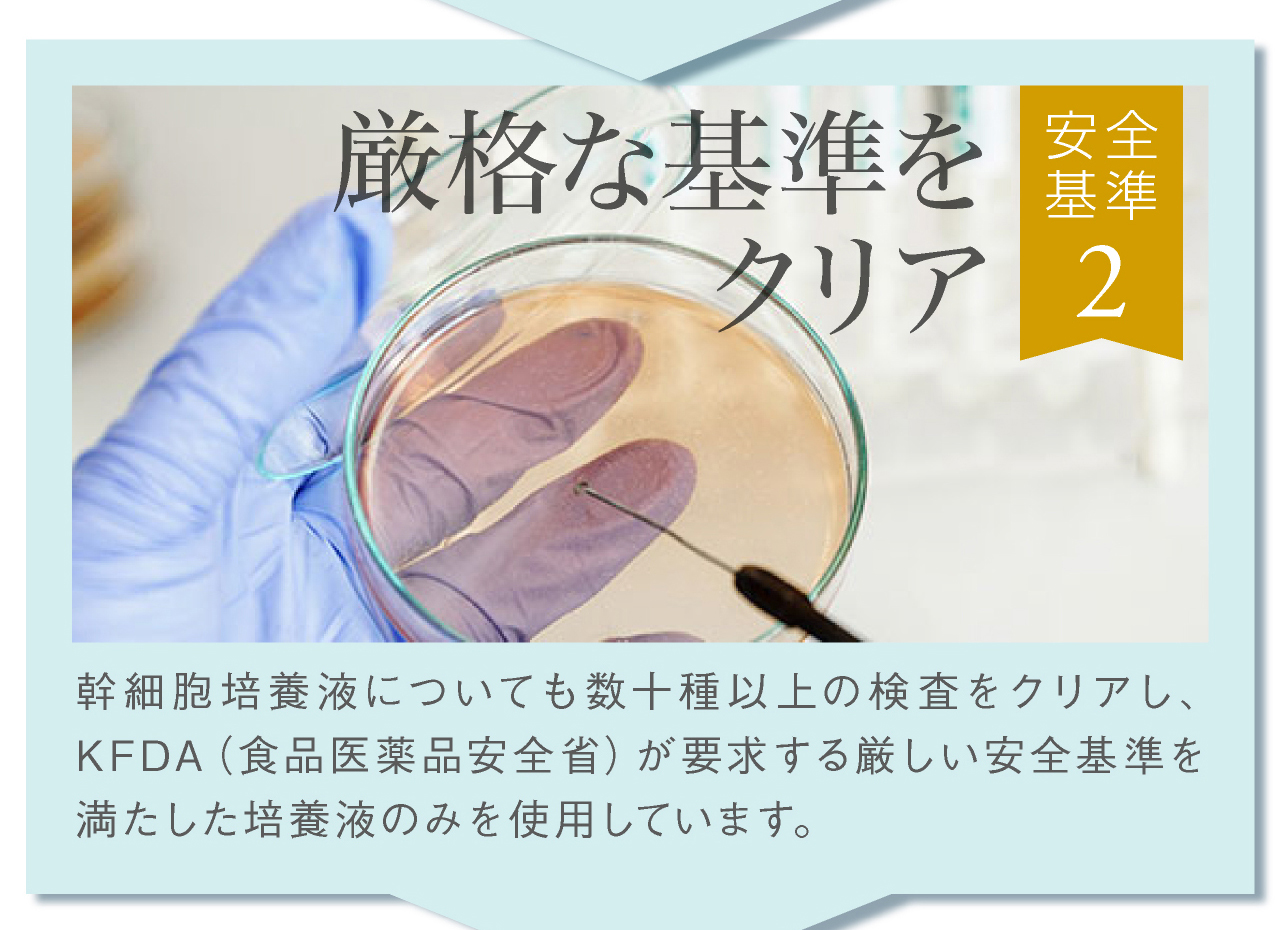
安全基準その2，厳格な基準をクリア。幹細胞培養液についても数十種以上の検査をクリアし、厳しい安全基準を満たした培養液のみを使用。

![]()
![]()
『セルラッシュプレミアム cell lush premium』
◇ 内容量:30mL
◇ 全成分:水、BG、ペンチレングリコール、ヒト脂肪細胞順化培養液エキス、プラセンタエキス、水溶性コラーゲン、ヒアルロン酸Na、グリセリン、プロパンジオール、オリーブ果実油、キサンタンガム、(クエン酸/乳酸/リノール酸/オレイン酸)グリセリル、ポリソルベート60、ポリグリセリン-10、パルミチン酸グリセリル、1,2-ヘキサンジオール、カプリリルグリコール、トロポロン、クエン酸、クエン酸Na、フェノキシエタノール
◇ ご注意:●お肌に合わないときは、ご使用をおやめください。●ご使用前に、二の腕等でお試しいただき、お肌に合うかをお確かめください。●傷、はれもの、湿しん等、異常のあるときは使用しないでください。●お肌に異常が生じていないかよく注意して使用してください。使用中、又は使用後直射日光にあたって、赤み、はれ、かゆみ、刺激、色抜け(白斑等)や黒ずみ等の異常が現れたときは使用を中止し、皮フ科専門医等へご相談することをおすすめします。そのまま化粧品類の使用を続けますと悪化することがあります。●乳幼児や認知症の方等の手の届かない場所に保管してください。